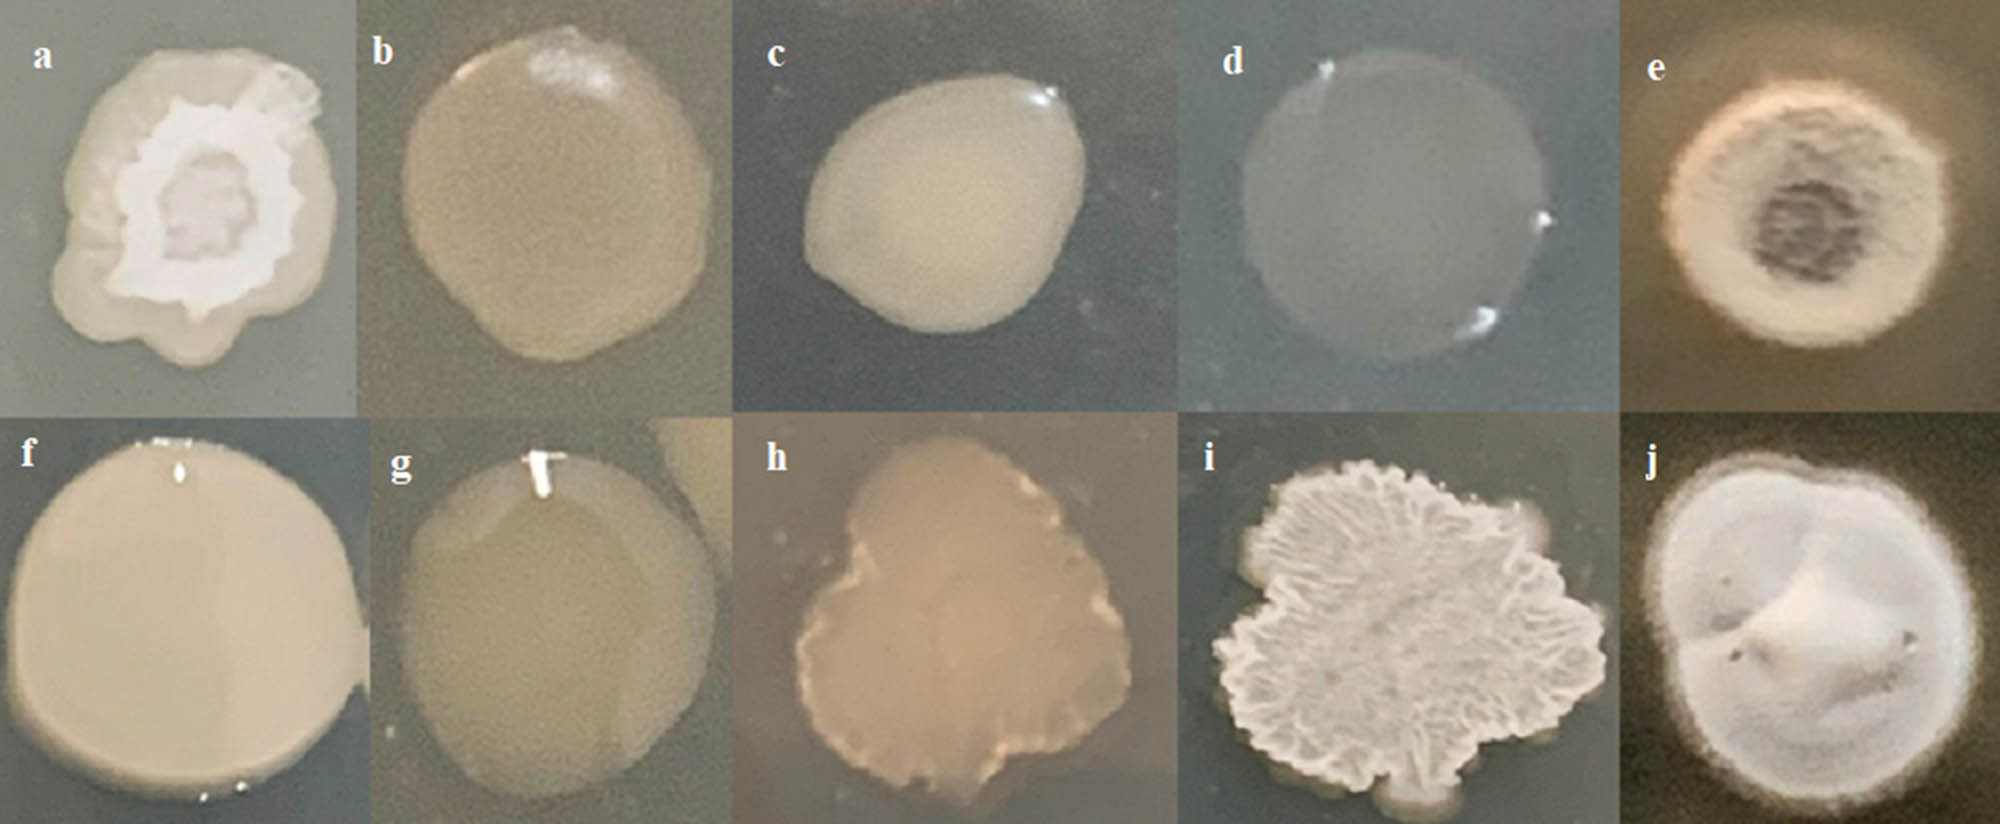
Figure 1 
                  Comparison of colony morphology of wild and mutant strains. (a) – B. subtilis BRBac4 (wild); (b, c, and d) – mutants of B. subtilis BRBac4 (b-M4, c-M6, d-M-8), (f) – B. siamensis BRBac21 (wild); (g, h, and i) mutants of B. siamensis BRBac21 (g – M2, h – M10, i – M12), (e) – S. cavourensis BRAcB10 (wild); (j) – mutant of S. cavourensis BRAcB10.

Gamma-induced mutants of Bacillus and Streptomyces display enhanced antagonistic activities and suppression of the root rot and wilt diseases in pulses
-
Ariyan Manikandan
, Iruthayasamy Johnson , Nanjundan Jaivel , Ramasamy Krishnamoorthy , Murugaiyan SenthilKumar , Rajasekaran Raghu , Nellaiappan Olaganathan Gopal , Prasun K. Mukherjee and Rangasamy Anandham
Abstract
This study aims to increase Bacillus and Streptomyces antagonistic activity against the root rot and wilt diseases of pulses caused by Macrophomina phaseolina and Fusarium oxysporum f. sp. udum, respectively. To increase antagonistic action, Bacillus subtilis BRBac4, Bacillus siamensis BRBac21, and Streptomyces cavourensis BRAcB10 were subjected to random mutagenesis using varying doses of gamma irradiation (0.5–3.0 kGy). Following the irradiation, 250 bacterial colonies were chosen at random for each antagonistic strain and their effects against pathogens were evaluated in a plate assay. The ERIC, BOX, and random amplified polymorphic studies demonstrated a clear distinction between mutant and wild-type strains. When mutants were compared to wild-type strains, they showed improved plant growth-promoting characteristics and hydrolytic enzyme activity. The disease suppression potential of the selected mutants, B. subtilis BRBac4-M6, B. siamensisi BRBac21-M10, and S. cavourensis BRAcB10-M2, was tested in green gram, black gram, and red gram. The combined inoculation of B. siamensis BRBac21-M10 and S. cavourensis BRAcB10-M2 reduced the incidence of root rot and wilt disease. The same treatment also increased the activity of the defensive enzymes peroxidase, polyphenol oxidase, and phenylalanine ammonia-lyase. These findings suggested that gamma-induced mutation can be exploited effectively to improve the biocontrol characteristics of Bacillus and Streptomyces. Following the field testing, a combined bio-formulation of these two bacteria may be utilised to address wilt and root-rot pathogens in pulses.
Introduction
Pulses are India’s most important protein dietary source, with minimal fat and high fibre and nutrient content [1]. India cultivates roughly 34% of the worldwide cultivable land for pulses and contributes 24% of the global pulses production [2]. However, productivity of pulses in India is extremely low (652 kg ha−1) (FAOStat, 2013). It is estimated that wilt and rot diseases cause 40–45% of the yield loss in pulses [3,4]. Fusarium oxysporum f. sp. udum and Macrophomina phaseolina are the primary pathogens responsible for wilt and root rot diseases in pulses, respectively. Traditional methods for controlling soil-borne fungal infections include fungicide treatment, fumigation, and crop rotation [5,6]. However, the use of fungicides has greater drawbacks, such as environmental pollution, negative impact on soil-beneficial bacteria and insects, and development of disease resistance to the specific fungicide [7,8]. As a result, alternate sustainable and environmentally beneficial solutions are required.
The antagonistic microorganisms are used as biocontrol agents, which is a cost-effective and environmentally beneficial technique of controlling phytopathogens [9,10]. Certain antagonistic rhizobacteria utilised as biocontrol agents also have plant growth-promoting properties [11]. Bacillus sp. [12–16], Pseudomonas sp. [12,17], Trichoderma spp. [18–20], and Streptomyces [21–25] were utilised to suppress Macrophomina root rot and Fusarium wilt in diverse crops. Various modes of action in disease control have been identified in these antagonistic bacteria, including the formation of antifungal metabolites, lytic enzymes [24,26–28], volatile chemicals [15], and the establishment of systemic resistance [8,27,29].
Natural microbial strains produce only trace levels of antifungal compounds. This is because they require these secondary metabolites for competitive advantage and do not overproduce them. Microorganisms have evolved regulatory systems that allow a strain to prevent overproduction of its metabolites. Hence, strain enhancement programmes are essential for commercial application [30]. The use of random mutagenesis to modify strains aids in the improvement of biocontrol abilities and/or the synthesis of antifungal metabolites. Chemical or physical mutagens (ultraviolet or gamma irradiation) are employed [31]. Gamma irradiation boosted Bacillus subtilis secondary metabolites and disease control abilities [32,33], Trichoderma harzianum protease activity [34–36], Streptomyces antibiotic synthesis [37–39], and Bacillus thuringiensis chitinase production [40].
B. subtilis BRBac4, Bacillus siamensis BRBac21, and Streptomyces cavourensis BRAcB10 isolated from the pulses rhizosphere previously demonstrated numerous plant growth-promoting features as well as antagonistic activity against both the fungal diseases, F. oxysporum f. sp. udum and M. phaseolina (unpublished data). Random mutagenesis was performed in B. subtilis BRBac4, B. siamensis BRBac21, and S. cavourensis BRAcB10 using gamma irradiation and the mutation was validated by ERIC, BOX, and random amplified polymorphic DNA (RAPD) studies. We then tested these effective mutants against F. oxysporum f. sp. udum and M. phaseolina in vitro and in pot culture in pulses.
Materials and methods
Microorganisms and growth conditions
B. subtilis BRBac4 (GenBank: MN165562), B. siamensis BRBac21 (GenBank: MN165655), and S. cavourensis BRAcB10 (GenBank: OK427229) were isolated from pulses rhizosphere soils and used for this study. Bacillus spp. and Streptomyces were grown in an incubator shaker at 28 ± 2°C in liquid nutrient and tryptic soya media, respectively. F. oxysporum sp. udum NAIMCC-F-01125 was obtained from the Indian Council of Agricultural Research, Maunath Bhanjan, Uttar Pradesh, India, and M. phaseolina BRMP1 (GenBank: MN165654) was previously isolated from disease-infected pulses and obtained from the Department of Agricultural Microbiology, Tamil Nadu Agricultural University, Coimbatore, India. At 28 ± 2°C, the fungal pathogens were cultured in potato dextrose agar medium.
Gamma-induced mutation
The mutation was carried out at the Gamma Chamber 5000 at the Board of Radiation and Institute of Technology, Department of Atomic Energy (DAE), in Mumbai, India. The mutation was carried out at the Gamma Chamber 5000 at the Board of Radiation and Institute of Technology, Department of Atomic Energy (DAE), in Mumbai, India as described by Afsharmanesha et al. [32]. Bacterial strains previously cultivated in liquid media were placed in cryovials in triplicate and directly exposed to various gamma irradiation dosages, namely 0.5, 1.0, 1.5, 2.0, 2.5, and 3.0 kGy. C60 had an efficiency of 2.2 kGy. Following irradiation, the bacteria were serially diluted up to 10−6 in 0.8% saline and plated on their respective growth medium. Mutant colonies were chosen based on the physical differences between them and their wild-type counterparts. All the Bacillus and Streptomyces colonies that were chosen as putative mutants were kept in their respective growth medium for further testing.
Screening of antifungal activity
Using the dual plate approach previously reported by Khan et al. [41], all of the selected colonies were tested for antifungal activity against the pathogens M. phaseolina and F. oxysporum sp. udum. On one side of the potato dextrose agar Petri plates, a 6 mm fungal disc was inserted and the bacterial stain was streaked immediately opposite the mycelial disc. As a control, a fungal disc with no bacterial inoculation was used. All of the plates were incubated for 7 days at 28 ± 2°C. The following formula was used to compute the percentage of fungal growth:
where C – mycelial growth in control, T – mycelial growth in the treatment plates.
DNA isolation, rep-polymerase chain reaction (PCR), and RAPD
The Hi-GenoMB Miniprep kit (Hi Media, India) was used to isolate DNA from wild and putative mutant Bacillus and Streptomyces strains. Extracted DNA was electrophoresed on 0.8% agarose gel and visualised in the Gel documentation unit (Vilber, Germany). For mutation confirmation, RAPD, ERIC, and BOX amplifications were performed [34]. The PCR mixture contains two PCR master kits (Sigma, India), 10 pmol of each primer (Table S1) (BioKart, Bengaluru), and 10 ng of genomic DNA. Initial denaturation at 95°C for 5 min was followed by 35 cycles of denaturation at 94°C for 30 s, annealing at 45°C (ERIC), 46°C (BOX), and 33°C (RAPD) for 1 min, and final extension at 72°C for 1 min. In 1% agarose gel, amplicons were electrophoresed.
PCR amplification of the antibiotic resistance gene
Two Bacillus and mutant colonies with significant antifungal activity were examined for the presence of lipopeptide genes (surfactin and iturin) [42]. Lipopeptide gene PCR amplification began with a 5 min denaturation at 95°C, followed by 30 cycles of denaturation (1 min at 94°C), annealing (1 min at 55°C), extension (1 min at 72°C), and final extension for 10 min at 72°C. Table S1 lists the primers utilised for the various lipopeptide genes.
Plant growth-promoting (PGP) traits
Indole acetic acid (IAA)
The synthesis of IAA was quantified using the previously reported method [43]. Overnight developed cultures were inoculated in 5 mL of nutrient broth containing 0.1% tryptophan and cultured for 72 h at 28 ± 2°C. The supernatant was then collected for 10 min at 12,000 rpm. Around 500 µL of supernatant was mixed with 50 µL of 0.1 mM ortho phosphoric acid and 2 mL of Salkowski reagents and incubated in the dark for 30 min to generate red colour. IAA was measured using a spectrophotometer at 530 nm (Systronics®, Spectrophotometer 166) and represented as µg mL−1.
Bacterial motility assays
The swimming and swarming motility of the bacterial strains B. subtilis BRBac4, B. siamensis BRBac21, and their mutations was measured using the method published previously [44]. For the swimming and swarming motility assays, Luria Bertani (LB) plates were altered with 0.3 and 0.7% agar, respectively. The plates were incubated for 18 h at 28 ± 2°C and the colony diameter was measured.
Phosphate solubilisation
In a plate assay, the selected Bacillus, Streptomyces, and their mutants were examined for phosphate solubilisation efficiency. Overnight grown bacterial strains were inoculated (1 × 107 CFU mL−1) into Pikovskaya’s agar medium and incubated for 48 h at 28 ± 2°C. Phosphate solubilisation was thought to be positive in the clear zone surrounding the bacterial colonies.
Hydrolytic activity
Chitinase activity
Chitinase activity was measured using the previously reported method [45]. The bacterial strains were cultivated in liquid nutrient medium enriched with 0.3% colloidal chitin and shaken for 24 h at 28 ± 2°C (100 rpm). The crude enzyme was then collected by centrifugation at 10,000 rpm for 20 min at 40°C. The reaction solutions were incubated at 35°C for 25 min with 0.3% colloidal chitin (0.1 mL), a crude enzyme solution (0.1 mL), and 0.1 M McIIvaine buffer of pH 6.0 (0.2 mL). The reaction was stopped by adding 2.0 mL of 1.5 mmol potassium ferricyanide reagent. A spectrophotometer (Systronics®, Spectophotometer166) was used to measure the final absorbance at 420 nm. The enzyme activity was measured in micromoles of N-acetyl glucosamine per minute.
Protease and cellulase activity
The skim milk agar medium was used to test the protease activity of Bacillus, Streptomyces, and their mutants. Overnight developed bacterial cultures were spotted (1 × 107 CFU mL−1) on skim milk agar medium and incubated for 72 h at 28 ± 2°C. The presence of a clean zone around the colonies suggested the presence of protease activity. To assess cellulase activity, nutrient agar medium was supplemented with 1% carboxy methyl cellulose instead of glucose, and 10 µL (1 × 107 CFU mL−1) of bacterial strains were spot inoculated. The plates were incubated for 72 h at 28 ± 2°C. Following the incubation period, the hydrolysis zone was seen by flooding the plates with 0.1% iodine solution for 15–20 min, after which the plates were rinsed with distilled water and destained with 1 M NaCl. The presence of translucent hydrolytic zones around the colonies showed the presence of positive cellulase activity [46].
Analysis of the volatile compounds
The volatile organic compounds (VOCs) of mutant Bacillus and Streptomyces strains were investigated using gas chromatography – mass spectrometry (GC-MS) and a thermal desorber (TD). In a 500 mL Erlenmeyer flask, the bacteria were inoculated into liquid nutrient medium. With the help of a rubber cork, a tenax-coated stainless-steel column was fitted with the flask. The VOCs collected by the column were analysed using TD-GC-MS on a TurboMatrix 150 (Perkin Elmer, USA). For separation, a non-polar capillary column (30 m, 250 µm) coated with 5% phenyl methyl siloxane was utilised. The following temperature regime resulted in volatile separation: the initial oven temperature of 50°C was increased to 250°C at a rate of 10°C per min; the injection port was kept in split mode with a 1:10 split ratio; and the carrier gas was helium at a constant flow rate of 0.7 mL min−1. The MS settings were as follows: full scan mode; scan range of 0.2 s at intervals of 0.1 s; electron impact spectra of 70 eV; and positive ion mode. By comparing the collected mass spectra to the NIST/EPA/NIH Mass Spectral Library, NIST 14, the VOC was identified. The approach described by Passari et al. [47] was used for VOC detection and analysis.
Effect of antagonistic mutants on suppression of root rot and wilt pathogens
Under pot culture conditions, the best-performing Bacillus and Streptomyces mutants were tested against the wilt and root rot pathogens. Red gram cv., Co (Rg)-7, Green gram cv., Co (Gg)-7, and Black gram cv.,Vamban 8 seeds were received from the Department of Pulses at Tamil Nadu Agricultural University in Coimbatore, India. The seeds were surface cleaned with 0.1% HgCl2 and washed four times with sterile distilled water before soaking for 30 min in Bacillus (108 CFU mL−1) and Streptomyces (108 CFU mL−1) mutants produced in their respective media. For pot culture study, soil and sand were taken in the ratio of 3:1 and 2 kg of this mixture were filled in a pot (18 cm outer diameter and 20 cm height) and 5 seeds were sown in each pot. In total, five pots were maintained for each treatment and each treatment was replicated four times. Treatment details in this study were T1 – B. subtilis BRBac4-M6, T2 – B. siamensis BRBac21-M10, T3 – S. cavourensis BRAcB10-M2, T4 – B. subtilis BRBac4-M6 + B. siamensis BRBac21-M10, T5 – B. subtilis BRBac4-M6 + S. cavourensis BRAcB10-M2, T6 – B. siamensis BRBac21-M10 + S. cavourensis BRAcB10-M2, T7 – B. subtilis BRBac4-M6 + B. siamensis BRBac21-M10 and S. cavourensis BRAcB10-M2, T8 – standard bio-control agent (Trichoderma viride), T9 – chemical fungicide Thiram, T10 – control (pathogen inoculated). Oatmeal medium was used to produce M. phaseolina inoculum. Mycelial discs were injected into the sterile oat meal medium and grown at 30°C. Before sowing the seeds of black gram and green gram, the inoculum (0.1% w/w) was combined. Inoculum of F. oxysporum f. sp. udum was made by adding 150 mL (2 × 108 spores mL−1) of broth per kilogram of soil and incubating for 7 days for spore germination. This inoculum was combined before to the sowing of red gram [48]. The plant defence enzyme was analysed 28 days after the seeds were sown (DAS). Plant samples were uprooted and taken to the laboratory for biometric measures after 35 DAS.
Enzyme analysis
After collecting 28 DAS leaf samples, they were pulverised with liquid nitrogen in a pre-chilled pestle and mortar. One gram of powdered leaf sample was combined with 2 mL of 0.1 M sodium phosphate buffer (pH 7.0), and the supernatant was collected after 15 min of centrifugation at 14,000 rpm at 4 C. The enzyme activity of peroxidase (PO), polyphenol oxidase (PPO), and phenylalanine ammonia-lyase (PAL) were determined using the supernatant.
PO, PPO, and PAL assay
PO activity was measured using the method described earlier [49]. The reaction mixture was composed of 0.5 mL of enzyme extract, 1.5 mL of 0.05 M pyrogallol, and 0.5 mL of 1% H2O2. The reaction mixture was incubated at 28 ± 2oC for 3 min, and the change in absorbance was recorded at 420 nm every 30 s. The boiled enzyme was added to the test mixture as a blank. PO activity was measured as a change in OD per minute per gram fresh weight. PPO activity was assessed using the method described by Park et al. [50]. Around 200 µL of enzyme extract and 1.5 mL of 0.1 M sodium phosphate buffer (pH 6.5) were used in the test. The reaction was started by adding 200 µL of 0.01 M catechol and the absorbance at 495 nm was measured. PPO activity was measured as a change in OD per minute per gram fresh weight. The PAL assay was carried out exactly as stated by Lee et al. [51]. The assay mixture was made up of 100 µL of enzyme extract, 500 µL of 50 mM tris-HCl (pH 8.8), and 600 µL of 1 mM L-phenylalanine, and it was incubated for 1 h. To stop the process, 2 N HCl was added. The mixture was then vortexed and centrifuged after 1.5 mL of toluene was added (1,000 rpm, 5 min). After separating the toluene phase, the trans cinnamic acid level was measured at 290 nm with a spectrophotometer (Systronics®, Spectophotometer166). A standard was prepared by using cinnamic acid in toluene. PAL activity is expressed as trans cinnamic acid per hour per gram fresh weight.
Statistical analysis
Analysis of variance was used to analyse all the data and the mean values were compared using Tukey’s honest significant difference test. The figures were created with the statistical software R and Origin pro. The PRIMER 7 programme was used to create the dendrograms.
Results
Screening of mutants
After gamma irradiation, 250 colonies were randomly picked for each antagonistic bacterial strain based on colony morphology (Figure 1). As a result, in a dual plate assay, all of the selected colonies were tested for antifungal activity against M. phaseolina and F. oxysporum sp. udum. The results revealed that mutant strains had stronger inhibitory action than their wild-type counterparts. The rate of inhibitory activity was found to be higher at 2,500 and 3,000 Gray radiation doses. M. phaseolina was inhibited by B. siamensis BRBac 21-M10 to a maximum of 69%. F. oxysporum sp. udum was inhibited by B. siamensis BRBac 21-M15 to a maximum of 56%. Also in S. cavourensis BRAcB10 M2 mutant showed the increased inhibition activities against the tested pathogens (Table 2; Figures S1 and S2).
Comparison of colony morphology of wild and mutant strains. (a) – B. subtilis BRBac4 (wild); (b, c, and d) – mutants of B. subtilis BRBac4 (b-M4, c-M6, d-M-8), (f) – B. siamensis BRBac21 (wild); (g, h, and i) mutants of B. siamensis BRBac21 (g – M2, h – M10, i – M12), (e) – S. cavourensis BRAcB10 (wild); (j) – mutant of S. cavourensis BRAcB10.
Analysis of rep-PCR, RAPD fingerprint patterns, and lipopeptide genes
Six primers were utilised to amplify the selected mutants and their wild types for fingerprinting analysis. The banding pattern of each primer differed from one another. In the mutants of B. subtilis BRBac4 and B. siamensis BRBac21, the BOX1AR showed four different types of bands ranging from 800 to ∼2,500 bp (Figure 2). The identical BOX1AR primer, however, produced nine distinct bands in the S. cavourensis BRAcB10 mutants, with amplicons spanning from ∼80 to 3,500 bp (Figure 2). For BRBac4 and BRBac21 mutants, the ERIC 1 R primer produced 6–7 bands with amplicons ranging from 300 to ∼3,000. In addition, 11 bands ranging from 180 to ∼2,500 were detected in BRAcB10 mutants (Figure 2). RAPD primers OPA9, OPA 10, OPA 18, and OPA 19 were used in this study. OPA 9 amplified 10 different bands ranging between 200 bp and ∼3,000 bp in BRBac4, BRBac21, and their mutants (Figure S3). OPA 9 exhibited 17 different amplicons which ranged from 100 to ∼2,500 bp in the BRAcB10 (Figure S4). OPA 10 amplified only 4 clear bands with a range of 700–1,500 bp for BRBac4 and BRBac21. OPA 10 showed 4–10 different bands in BRAcB10 with the amplicon size of 350 to ∼2,500 bp. The other RAPD primer OPA 18 and OPA 19 results are also given in Figures S3 and S4.

ERIC, BOX fingerprinting pattern in wild and mutants strains of B. subtilis BRBac4, B. siamensis BRBac21, and S. cavourensis BRAcB10. BOX (i), ERIC (ii) of B. subtilis BRBac4 and their respective mutants. Lanes 1–11 (1-M1, 2-M2, 3-M3, 4-M4, 5-M5, 6-M6, 7-M7, 8-M8, 9-M9, 10-M10, and 11-M11). BOX (iii), ERIC (iv) of B. siamensis BRBac21 and their respective mutants. Lanes 1– 11 (1-M1, 2-M2, 3-M3, 4-M4, 5-M5, 6-M6, 7-M7, 8-M8, 9-M9, 10-M10, and 11-M11). BOX (v), ERIC (vi) of S. cavourensis BRAcB10 and their respective mutants. Lanes 1–14 (1-M1, 2-M2, 3-M3, 4-M4, 5-M5, 6-M6, 7-M7, 8-M8, 9-M9, 10-M10, and 11-M11); Lane W – Wild strains, L – 100 bp DNA Ladder.).
In this study, all of the primers examined exhibited a considerable amount of polymorphism in all of the strains tested. Furthermore, the presence and disappearance of bands was revealed to be a clear difference between the RAPD and rep-PCR fingerprint profiles of wild and mutant colonies. For example, the BOXA1R primer showed only four bands in BRBac4 except the M8 mutant, it showed the additional 5 bands in ∼1,000 to ∼1,500 bp. Similarly, in the BRBac21, two mutants showed additional bands in ∼150, ∼250, and ∼450 bp. Likewise in the BRAcB10, two mutants showed a higher intensity of few extra bands compared to its wild types. The ERIC 1R primer, bands were observed with the molecular weight of 200, ∼550, 600, 1,000, 1,500, and one additional band at ∼2,500 bp which was absent in mutants M10 and M11 of BRBac4. In BRBac21, ∼2,500 bp amplicon was absent in mutants while it was noticed in wild type. Also in BRAcB10, ERIC 1R primer showed the 11 bands with some additional bands at ∼650 and ∼1,200 bp were also noticed in mutants which were not observed in wild-type strains. The band with a molecular weight of 700 bp, on the other hand, was missing in BRAcB10 mutants. Amplification of lipopeptide genes such as iturin A (∼650 bp) and surfaction (∼440 bp) from BRBac4 and BRBac21 isolates was confirmed.
Cluster analysis of the rep-PCR and RAPD fingerprints
To separate the wild-type strains and their mutants, cluster analyses were done using data from rep-PCR and RAPD primers. The resulting dendrogram revealed a 91% similarity level between the mutants of B. subtilis BRBac4 and their wild type (Figure 3). Cluster I contained 50% of the isolates, together with the wild type; the remaining mutants belonged to Cluster II. Dendrogram results for B. siamensis BRBac21 and its mutants demonstrated 92% similarity. Cluster I included just two mutants of BRBac21, M11 and M12. Cluster II contained the remaining mutants and wild types. Similarly, the dendrogram of S. cavourensis BRAcB10 and its mutants showed 73% similarity, with two clusters. Cluster I accounted for 41.66% of the mutants among the two clusters. Cluster II contained the remaining 58.3% mutants and wild-type strains (Figure 3).

Dendrogram of B. subtilis BRBac4, B. siamensis BRBac21, S. cavourensis BRAcB10 and their mutants from fingerprint data of ERIC, BOX, and RAPD.
In vitro screening for plant growth-promoting traits
Among the mutants studied, B. subtilis BRBac4-M8 had the highest phosphate solubilisation efficiency (182.45%), followed by BRBac4-M6 (179.12%) and BRBac21-M10 had the lowest (153.25%) (Table 1). All Bacillus and Streptomyces mutants had an orange clear zone around the colonies, indicating that they were producing siderophores. When compared to wild types, mutants produced significantly less IAA. The highest level of IAA was found in B. subtilis BRBac 4 (16.4 µg mL−1), while the lowest amount was found in S. cavourensis BRAcB10-M4 (3.1 µg mL−1) (Table 1). In 0.3% agar containing LB medium, all wild and mutant Bacillus showed greater rates of swimming motility; however, in swarming motility B. subtilis BRBac4-M6 only exhibited the minimal range of swarming motility (Figure S5).
Pathogen inhibition, production of hydrolytic enzymes and PGP traits of mutants and wild strains of Bacillus and Streptomyces
| Isolates | Inhibition in dual plate assay (%) | Chitinase activity (µM min−1 mL−1) | Protease (%) | IAA production (µg mL−1) | Phosphate solubilisation (%) | Cellulase activity (%) | |
|---|---|---|---|---|---|---|---|
| M. phaseolina | F. oxysporum f. sp. udum | ||||||
| BRBac 4 (wild) | 59.4 ± 2.3efgh | 49.1 ± 1.5efg | 2634.00 ± 31.0b | 66.67 ± 0.2g | 16.4 ± 0.15a | 176.6 ± 6.2bc | 118 ± 2.99gh |
| BRBac 4-M1 | 61 ± 0.8def | 53 ± 1.0bcd | 2489.56 ± 37.3c | 80.00 ± 1.5f | 12.1 ± 0.34g | 156 ± ± 4.56f | 124 ± 3.54 efg |
| BRBac 4-M4 | 59 ± 0.9fgh | 52 ± 1.5cde | 2567.33 ± 48.9bc | 98.18 ± 2.2c | 10.6 ± 0.29i | 148 ± 0.20h | 136 ± 0.09bcd |
| BRBac 4-M6 | 67 ± 0.2ab | 59 ± 1.8a | 2822.89 ± 42.3a | 103.00 ± 2.2b | 11.2 ± 0.25h | 179 ± 4.99ab | 121 ± 3.70fgh |
| BRBac 4-M8 | 63 ± 0.6cde | 43 ± 1.2i | 2300.67 ± 20.4 | 85.00 ± 2.5de | 9.7 ± 0.01j | 182 ± 4.5a | 128 ± 1.74def |
| BRBac 21 (wild) | 62.9 ± 1.2cde | 45.6 ± 0.2ghi | 1778.44 ± 7.3e | 96.67 ± 1.1c | 13.4 ± 0.33de | 159 ± 1.11ef | 113 ± 1.46h |
| BRBac 21 M1 | 65 ± 0.9bc | 48 ± 0.4fgh | 1656.22 ± 22.5f | 128.57 ± 3.8a | 12.8 ± 0.31f | 172 ± 2.81cd | 124 ± 2.45efg |
| BRBac 21 M2 | 59 ± 0.2fgh | 51 ± 1.2cdef | 1208.07 ± 23.0h | 83.33 ± 0.3ef | 13.1 ± 0.02ef | 168 ± 1.03e | 132 ± 1.08cde |
| BRBac 21 M10 | 69 ± 1.9a | 53 ± 1.2bcd | 745.11 ± 21.8k | 87.50 ± 0.7d | 15.6 ± 0.21b | 153 ± 2.19fg | 117 ± 2.87gh |
| BRBac 21 M12 | 64 ± 0.7bcd | 50 ± 0.4def | 1411.78 ± 35.5g | 80.00 ± 2.3d | 14.5 ± 0.15c | 172 ± 4.21cd | 121 ± 3.05fgh |
| BRBac 21 M15 | 60 ± 0.7efg | 56 ± 0.7ab | 1334.00 ± 11.8g | 37.50 ± 0.7h | 13.7 ± 0.23d | 175 ± 2.62bc | 126 ± 0.17efg |
| BRAcB10 (wild) | 54 ± 0.6ijk | 51 ± 1.0cdef | 834.00 ± 13.6jk | 0.36 ± 0.01i | 3.8 ± 0.05m | ND | 137 ± 3.73bc |
| BRAcB10-M2 | 57 ± 1.2ghi | 48 ± 1.2fgh | 896.96 ± 22.6ij | 0.36 ± 0.02i | 4.8 ± 0.13l | ND | 141 ± 0.58ad |
| BRAcB10-M2 | 56 ± 0.5hij | 52 ± 0.4cde | 912.45 ± 7.0ij | 0.47 ± 0.01i | 5.8 ± 0.06k | ND | 125 ± 2.58 efg |
| BRAcB10-M3 | 51 ± 1.1k | 45 ± 0.4hi | 1010.25 ± 3.4i | 0.81 ± 0.03i | 4.9 ± 0.11l | ND | 148 ± 0.50a |
| BRAcB10-M4 | 53 ± 1.0jk | 50 ± 1.6def | 837.25 ± 7.4jk | 0.68 ± 0.01i | 3.1 ± 0.07n | ND | 142 ± 2.51ab |
| BRAcB10-M5 | 55 ± 0.9ijk | 54 ± 0.3bc | 925.24 ± 24.6ij | 0.72 ± 0.02i | 5.7 ± 0.12k | ND | 135 ± 0.55bcd |
Values are mean of three replicates ± standard errors. Means sharing common letter(s) in each column do not differ significantly at P > 0.05. ND – not detected. BRBac4 – B. subtilis, BRBac 21 – B. siamensis, and BRAcB10 – S. cavourensis. M stands for respective mutants.
Screening for hydrolytic enzymatic activity
B. subtilis BRBac4-M8 had the highest chitinase activity of 2822.89 µM min−1 mL−1, whereas S. cavourensis BRAcB10-M4 had the lowest at 837.25 µM min−1 mL−1 (Table 1). The maximal proteolytic activity was identified in B. siamensis BRBac21-M1 (128.57%) with a small quantity of proteolytic activity found in other Streptomyces and its mutants. Bacillus and Streptomyces mutants all had positive cellulase activity. Cellulase levels were highest (148%) and lowest (113%) in S. cavourensis BRAcB10-M3 and B. siamensis BRBac21, respectively (Table 1).
Analysis of the volatile compounds
The TD-GC-MS analysis of VOCs from chosen mutants of B. subtilis BRBac4, B. siamensis BRBac21, and S. cavourensis BRAcB10 revealed a total of 26 compounds (Table S2). Cyclotrisiloxane (6.7%), hexane (24.1%), carbon disulphide (1.9%), 1,4-pentadiene (6.8%), and cyclopropane were the most abundant volatiles generated by the BRBac21 mutant (6.1%). Furan 2 methyl (28.9%), 1,4-pentadiene (6.9%), carbon disulphide (0.2%), and tetrahydroxybutyl imidazole are all present in BRBac4 (7.6%). Similarly, furan 2 methyl occupied the most amount (38.7%) in BRAcB10, followed by disulphide, dimethyl (10.3%), carbon disulphide (1.8%), 1-pentanol (10.3%), and dodecane (0.7%). Carbon disulphide, dimethyl disulphide, benzoic acid, xylene, phenol, dodecane, and benzothiazole are among the recognised volatile chemicals that play an important role in biocontrol and plant growth-promoting qualities. The row Z score values for the VOCs were acquired from the heat map (Figure S6). The Z score on the heat map ranged from 0 to 1. Cyclopropane, butane 2 methyl, cyclohexane, methylene chloride, and hexane all showed Z scores greater than one in BRBac4 VOCs (Figure S6). Furan 2 methyl, benzothiazole, formic acid, and cyclopropane all had multiple Z scores in BRBac21. Further, the Z scores of dimethyl trisulphide, disulphide dimethyl, xylene, phenol, benzothiazole, and carbon disulphide are greater than one in BRAcB10.
Antagonistic effects on wilt and root rot disease
The disease symptoms were discovered after the plant had germinated. The control (T9) treatment had a higher percentage of disease occurrence, 89 and 92% in the black and green gram, respectively, followed by T1 (B. subtilis [57 and 53%]) and T2 (BRBac4-M6 B. siamensis BRBac21-M10 [49 and 51%]), while T6 (B. siamensis BRBac21-M10 + S. cavourensis BRAcB10-M2). showed the minimum of 19 % root rot incidence in black gram and 19.5% in green gram (Figure 4). Red gram treated with F. oxysporum f. sp. udum exhibited wilt symptoms. Compared to root rot, the maximum wilt incidence (90.2%) was noticed in pathogen inoculated control, followed by T1 (53%) and T3 (45%). Minimum wilt disease incidence of 14.2 and 17.5%, was observed in T9 – fungicide (Thiram @ 4 g kg−1) and T6 – (B. siamensis BRBac21-M10 + S. cavourensis BRAcB10-M2), respectively (Figure 4).

Root rot disease incidence (a) on black gram and green gram and wilt incidence (b) on the red gram. T1 – B. subtilis BRBac4-M6, T2 – B. siamensis BRBac21-M10, T3 – S. cavourensis BRAcB10-M2, T4 – B. subtilis BRBac4-M6 + B. siamensis BRBac21-M10, T5 – B. subtilis BRBac4-M6 + S. cavourensis BRAcB10-M2, T6 – B. siamensis BRBac21-M10 + S. cavourensis BRAcB10-M2, T7 – B. subtilis BRBac4-M6 + B. siamensis BRBac21-M10, and S. cavourensis BRAcB10-M2, T8-Standard biocontrol agent (T. viride), T9-Chemical fungicide Thiram, T10 – Control (pathogen inoculated).
In leaf samples collected on 28 DAS, various defensive enzymes were examined. T5 (B. subtilis BRBac4-M6 + S. cavourensis BRAcB10-M2) had the highest PAL activity (149 µg cinnamic acid h−1 g−1 fresh wt) in green gram, followed by T4 (B. subtilis BRBac4-M6 + B. siamensis BRBac21-M10). T10 had the lowest amount of PAL activation (pathogen alone). Similar patterns were seen in red gram and black gram (Table 2). T6 (B. siamensis BRBac21-M10 + S. cavourensis BRAcB10-M2) had a higher degree of PO activity (0.42 changes in OD min−1 g−1 fresh wt) in black gram, followed by T5 – B. subtilis BRBac4-M6 + S. cavourensis BRAcB10-M2 (0.39 changes in OD min−1g−1 fresh weight). The T10 treatment (pathogen alone) exhibited the minimum level of PO activity compared to all other treatments. In the case of PPO, the higher activity (0. 0.164 changes in OD min−1 g−1 fresh wt) was noticed in T6, followed by T5 (0.37 changes in OD min−1 g−1 fresh wt) in red gram. The least PPO activity was noticed (0.074 changes in OD min−1 g−1 fresh wt) in T10 and the same trends were noticed in green gram and black gram (Table 2).
Induction of defense enzyme in pulses by mutant Bacillus and Streptomyces against F. udum and M. pahseolina
| Treatments | Phenylalanine ammonia-lyase (cinnamic acid h− 1 g− 1 fresh wt) | PPO (Δ changes in absorbance min− 1 g− 1 fresh wt) | PO (Δ changes in absorbance min−1 g−1 fresh wt) | ||||||
|---|---|---|---|---|---|---|---|---|---|
| Red gram | Green gram | Black gram | Red gram | Green gram | Black gram | Red gram | Green gram | Black gram | |
| T1 | 110 ± 0.19gh | 120 ± 2.05ef | 117 ± 2.55gh | 0.098 ± 0.0018f | 0.102 ± 0.0002b | 0.112 ± 0.0009f | 0.29 ± 0.0068d | 0.29 ± 0.0021e | 0.22 ± 0.0017f |
| T2 | 128 ± 3.83cde | 128 ± 1.74cde | 128 ± 1.65def | 0.112 ± 0.0034de | 0.098 ± 0.0027bc | 0.121 ± 0.0006ef | 0.34 ± 0.0032b | 0.31 ± 0.0059cd | 0.27 ± 0.0033de |
| T3 | 131 ± 1.96bcd | 131 ± 4.28cd | 139 ± 0.47bc | 0.109 ± 0.0015de | 0.102 ± 0.0004b | 0.134 ± 0.0005cd | 0.38 ± 0.0018a | 0.34 ± 0.0093b | 0.25 ± 0.0043e |
| T4 | 138 ± 4.41b | 141 ± 0.96ab | 145 ± 4.64ab | 0.135 ± 0.0021b | 0.112 ± 0.0037a | 0.167 ± 0.0016a | 0.37 ± 0.0028a | 0.38 ± 0.0109a | 0.31 ± 0.0082c |
| T5 | 152 ± 4.65a | 143 ± 3.60a | 149 ± 1.62aa | 0.137 ± 0.0022b | 0.117 ± 0.0006a | 0.171 ± 0.0006a | 0.34 ± 0.0067b | 0.34 ± 0.0106b | 0.39 ± 0.0048b |
| T6 | 134 ± 2.92bc | 130 ± 1.95cd | 128 ± 3.92de | 0.164 ± 0.0047a | 0.114 ± 0.0019a | 0.162 ± 0.0042ab | 0.39 ± 0.0011a | 0.38 ± 0.0103a | 0.42 ± 0.0111a |
| T7 | 118 ± 0.64fg | 134 ± 2.64bc | 132 ± 0.54cd | 0.125 ± 0.0027c | 0.098 ± 0.0017bc | 0.154 ± 0.0048b | 0.31 ± 0.0044c | 0.32 ± 0.0046c | 0.38 ± 0.0023b |
| T8 | 124 ± 0.34def | 131 ± 3.39cd | 124 ± 4.05defg | 0.114 ± 0.0028d | 0.097 ± 0.0030bc | 0.142 ± 0.0016c | 0.28 ± 0.0011d | 0.30 ± 0.0037de | 0.28 ± 0.0051d |
| T9 | 121 ± 0.58ef | 124 ± 1.35de | 120 ± 0.24eg | 0.102 ± 0.0017f | 0.094 ± 0.0001c | 0.124 ± 0.0023de | 0.28 ± 0.0021d | 0.29 ± 0.0032e | 0.26 ± 0.0050de |
| T10 | 107 ± 0.15h | 114 ± 0.39f | 108 ± 3.16h | 0.074 ± 0.0005g | 0.065 ± 0.0004d | 0.091 ± 0.0007g | 0.25 ± 0.0032e | 0.22 ± 0.0067f | 0.21 ± 0.0027f |
Values are mean of three replicates ± standard errors, means sharing common letter(s) in each column do not differ significantly at P > 0.05. T1 – B. subtilis BRBac4-M6, T2 – B. siamensis BRBac21-M10, T3 – S. cavourensis BRAcB10-M2, T4 – B. subtilis BRBac4-M6 + B. siamensis BRBac21-M10, T5 – B. subtilis BRBac4-M6 + S. cavourensis BRAcB10-M2, T6 – B. siamensis BRBac21-M10 + S. cavourensis BRAcB10-M2, T7 – B. subtilis BRBac4-M6 + B. siamensis BRBac21-M10 and S. cavourensis BRAcB10-M2, T8 – standard bio-control agent (T. viride), T9 – chemical fungicide Thiram, T10 – control (pathogen inoculated).
At 35 DAS, root and shoot lengths were measured. T6 (B. siamensis BRBac21-M10 + S. cavourensis BRAcB10-M2) had the longest root and shoot lengths, followed by T7 (B. subtilis BRBac4-M6 + B. siamensis BRBac21-M10 + S. cavourensis BRAcB10-M2). When compared with individual inoculation, combined inoculation resulted in longer root and shoot lengths (Figure S7). Nonetheless, for all the studied crops, the treatments T10 (pathogen infected control) had the shortest shoot and root lengths (Figure S7).
Discussion
Strain improvement is essential during the natural product commercialisation process, as the low titer of wild-type strains can never match the criteria of industrial development and sales [52]. The “random mutation and screening” technique has proven itself numerous times over the last century, making it the best option for strain enhancement today and in the foreseeable future. Mutation is a commonly utilised method in beneficial microorganisms for strain development in order to increase secondary metabolite production and antagonistic activity against diverse pathogens [53]. Ethyl methanesulphonate, hydroxylamine, methyl methanesulphonate, and N-methyl-N-nitro-N-nitroso guanidine are the most commonly used chemical mutagens. Physical approaches, like UV and gamma irradiation, can also be used to induce mutations [54]. The most popular way for obtaining high yielding mutants is to treat a population with a mutagenic agent until a specific “desired” kill is attained, plate out the survivors, and then test each resulting colony or a randomly selected group of colonies in flasks for product creation [30].
Random mutation was conducted in this study using gamma irradiation at different doses ranging from 0.5 to 3 kGy for both Bacillus and Streptomyces. The results showed that greater gamma-irradiated doses, such as 2.5 and 3 kGy, had a higher level of antifungal action. At dosages of 2, 2.5, and 3 kGy, antagonistic mutants of B. subtilis BRBac4-M4, BRBac4-M6, BRBac4-M8, B. siamensis BRBac21-2, BRBac21-10, BRBac21-15, and S. cavourensis BRAcB10-M2 were produced. These findings are consistent with those of Afsharmanesh et al. [33], who discovered that gamma-irradiated Bacillus subtilis UTB1 mutants increased biosurfactant synthesis and control of Aspergillus flavus. Trichoderma virens treated with gamma rays produced two to three times as many secondary metabolites [55]. Ion beam implantation resulted in increased surfactin synthesis in B. subtilis E8 [56]. Gamma irradiation was also used to boost antibiotic paromomycin synthesis in S. rimosus subsp. paromomycinus. In addition, when compared with natural strains, this mutant produced 1.4–2 times the amount of paromomycin [38]. Through the DNA repair systems within cells, gamma ray irradiation may cause certain mutations in cell genes [57,58]. Following 250 Gy of gamma irradiation, C/G base repair substitutions were the most common form of gamma ray induced mutations in Escherichia coli and spontaneous mutational hot spots around positions 620–632 in the lacI gene were reduced [59]. Gamma irradiation may have also boosted the expression of genes responsible for lipopeptides, antifungal metabolites, and plant growth-boosting characteristics in this study. However, it will need to be verified in the future using whole genome sequencing and transcriptome analysis.
Genomic rep-PCR fingerprinting is a technique for identifying and classifying bacteria. This technique is highly reliable, reproducible, and fast [60], and it is utilised to disclose the molecular diversity in the bacterial genome. As a result, this approach was used to determine the genome modification after gamma irradiation in contrast to wild strains. Afsharmanesh et al. [32] used rep-PCR fingerprinting to compare the genomic diversity and polymorphic bands of Bacillus subtilis UTB1 gamma-irradiated mutants with wild-type strains. Abbasi et al. [34], like us, used rep-PCR and RAPD techniques to identify variance in natural and gamma-induced mutant strains of T. harzianum. Several investigations have found that gamma-irradiation can change enzyme activity and secondary metabolites in microorganisms [61,62]. Soufi et al. [35] used rep-PCR (ERIC and BOX) to distinguish the gamma mutation from wild Trichoderma aureoviride strains. T. aureoviride mutants Tv3, Tv2, Tv6, Tv4, and Tv23 showed no genetic resemblance to wild and significantly improved biocontrol abilities in plate experiment. Gomaa and El-Mahdy [40] used gamma mutation to enhance chitinase output in B. thuringiensis NM101-19 and the mutants were screened using the RAPD and inter simple sequence repeat techniques. Rep-PCR (ERIC, BOX) and RAPD primers were examined for B. subtilis BRBac4, B. siamensis BRBac21, and S. cavourensis BRAcB10 and its mutants, resulting in significant differences in the wild type and mutant genomes. In B. subtilis BRBac4-M8, box primer produced bands at 450, 1,000, 1,200, and 1,300 bp, separating this mutant from its wild type (Figure 2). B. siamensis BRBac21-M4 exhibited extra bands of 150, 250, and 400 bp. These bands are most likely associated to the genes that control the expression of mycolytic enzymes, although more research is needed to prove this. Bacillus and Pseudomonas species produce lipopeptides which are antibacterial substances [63,64]. Surfactin, fengycin, and iturin are the three primary lipopeptides secreted by Bacillus spp. [65,66]. Surfactin and iturin genes were found in both B. subtilis BRBac4 and B. siamensis BRBac21 in this investigation. This is consistent with the findings of Gond et al. [42], who discovered the iturin gene as well as additional lipopeptide genes in B. subtilis.
In this study, pot culture data demonstrated that biocontrol agents inoculated treatments had longer root and shoot lengths than controls. Plant development was considerably increased by plant growth promoting rhizobacteria (PGPR) characteristics through both direct and indirect routes. According to Mehmood et al. [67], the use of biocontrol chemicals improved seed germination, root and shoot lengths, and dry biomass. Siderophore producing B. subtilis reduced the frequency of F. oxysporum wilt in cotton and also demonstrated numerous PGPR features such as IAA, 1-aminocyclopropane-1-carboxylic acid (ACC) deaminase, and phosphate solubilisation [68]. Several studies found that Bacillus spp. and Streptomyces isolated from the rhizosphere demonstrated phosphate solubilisation and antagonism against Fusarium spp. and other phytopathogens [69–71]. In chickpea and lentil, a mutant of T. virens outperformed natural strains in terms of antagonistic capacity against Sclerotium rolfsii. Mukherjee et al. and Yandigeri et al. [55,72] revealed that numerous strains of Streptomyces produced more IAA, which boosted wheat crop growth and yield. Bacillus amyloliquefaciens isolated from potato rhizosphere soil showed increased IAA and phosphate solubilisation efficiency, as well as antagonistic activity against Rhizoctonia solani and F. solani. Various Bacillus spp. exhibited ACC deaminase activity, which has a significant impact on plant development and biochemical properties [73,74]. Many actinobacterial taxa with ACC deaminase activity have been identified, including Streptomyces, Amycolatopsis, Mycobacterium, Rhodococcus, and Nocardia [75]. Hydrolytic enzymes (such as cellulase, protease, chitinases, amylase, lipase, and pectinase) have enhanced the PGPR properties associated with the control of plant fungal infections via cell wall disintegration [76]. Our strains also tested positive for a variety of hydrolytic enzymes. Several investigations have found that Bacillus spp. [8,77,78] and Streptomyces [79,80] produce mycolytic enzymes that efficiently suppress fungal infections.
Several previous studies [81,82] found that VOC might inhibit fungal infections. B. subtilis and Actinomyces produce VOCs such as alcohols, ketones, aldehydes, acids, hydrocarbons, and S-containing chemicals [62,80]. In the B. subtilis BRBac4-M6, B. siamensis BRBac21-M10, and S. cavourensis BRAcB10-M2 mutants, approximately 26 compounds were discovered. VOC chemicals generated by mutants demonstrated similarity to their wild-type counterparts (unpublished data). B. siamensis BRBac21 wild strain generated 31.4% Furan, 2-methyl, which was also observed in the BRBac21-10 mutant (28%). Similarly, 4.8 and 6% of 1-pentadiene were found in BRBac21 and its mutant BRBac21-10, respectively. When mutants are compared with wild strains, certain novel chemicals are discovered (Table S2). When compared to the control, the activity of plant defence enzymes was relatively elevated in all treatments. Similar to these findings, other studies have found enhanced production of defence enzymes such as PAL, PO, and PPO in bacterial inoculation treatments compared with controls [8,83,84]. Many studies have found that the PGPR aids in plant defence response to pathogen invasion by possibly increasing chitinase activity, siderophore synthesis, and protease activity [85–87]. In this study, highly effective mutants due to gamma irradiation, B. siamensis BRBac21-M10 and S. cavourensis BRAcB10-M2, were chosen for investigation based on their enhanced antifungal activity against M. phaseolina and F. oxysporum f. sp. udum.
Conclusion
Mutant Bacillus and Streptomyces strains displayed significantly better antagonistic activity against M. phaseolina and F. oxysporum f. sp. udum compared with wild-type bacteria, owing to increased synthesis of lipopeptides, hydrolytic enzymes, and swarming and swimming motilities. Analyses of DNA fingerprinting revealed significant polymorphisms between wild type and mutant strains. The combined inoculation of B. siamensis BRBac21-M10 + S. cavourensis BRAcB10-M2 resulted in the lowest incidence of root rot and wilt disease. In addition, the same treatment increased the activity of the defence enzymes PO, PPO, and PAL in pot culture conditions, indicating that, in addition to direct antagonism, these bacteria generated systemic resistance in pulses. These findings suggested that gamma-induced mutation can be used effectively to improve the biocontrol characteristics of Bacillus and Streptomyces. In conclusion, after field testing in multiple places, a combination bio-formulation of these two rhizobacteria may be used to address wilt and root rot pathogens in pulses.
Acknowledgements
The authors are grateful to the Department of Agricultural Microbiology, Tamil Nadu Agricultural University for infrastructure assistance.
-
Funding information: This study was supported by Government of India, Board of research in nuclear science (GoI-BRNS), and Department of Atomic energy (DAE. 35/14/17/2018-BRNS/10395).
-
Author contributions: RA conceptualised the research, designed the experiments, and corrected the manuscript, AM, NJ, and IJ conducted experiments, RK drafted the manuscript, PKM designed the experiments and corrected the manuscript, NOG and MS analysed metabolites in GC-MS.
-
Conflict of interest: Authors state no conflict of interest.
-
Data availability statement: The datasets generated during and/or analysed during the current study are available from the corresponding author on reasonable request.
References
1 Varshney RK, Song C, Saxena RK, Azam S, Yu S, Sharpe AG, et al. Draft genome sequence of chickpea (Cicer arietinum) provides a resource for trait improvement. Nat Biotechnol. 2013;31:240–6.10.1038/nbt.2491Search in Google Scholar
2 Barik AK. Pulse cultivation-a venture for food, nutrition and livelihood. Int J Bio-Resource Stress Manag. 2021;12:i–ii. 10.23910/1.2021.2192b.Search in Google Scholar
3 Iqbal U, Mukhtar T. Evaluation of biocontrol potential of seven indigenous Trichoderma species against charcoal rot causing fungus, Macrophomina phaseolina. Gesunde Pflanz. 2020;72:195–202.10.1007/s10343-020-00501-xSearch in Google Scholar
4 Ramyabharathi SA, Meena B, Raguchander T. Induction of chitinase and β-1, 3-glucanase PR proteins in tomato through liquid formulated Bacillus subtilis EPCO 16 against Fusarium wilt. J Today’s Biol Sci: Res Rev India. 2012;1:50–60.Search in Google Scholar
5 Wang L, Li X. Steering soil microbiome to enhance soil system resilience. Crit Rev Microbiol. 2019;45:743–53.10.1080/1040841X.2019.1700906Search in Google Scholar
6 Tang L, Xia Y, Fan C, Kou J, Wu F, Li W, et al. Control of Fusarium wilt by wheat straw is associated with microbial network changes in watermelon rhizosphere. Sci Rep. 2020;10:1–14.10.1038/s41598-020-69623-6Search in Google Scholar
7 Budi SW, van Tuinen D, Arnould C, Dumas-Gaudot E, Gianinazzi-Pearson V, Gianinazzi S. Hydrolytic enzyme activity of Paenibacillus sp. strain B2 and effects of the antagonistic bacterium on cell integrity of two soil-borne pathogenic fungi. Appl Soil Ecol. 2000;15:191–9.10.1016/S0929-1393(00)00095-0Search in Google Scholar
8 Dukare A, Paul S. Biological control of Fusarium wilt and growth promotion in pigeon pea (Cajanus cajan) by antagonistic rhizobacteria, displaying multiple modes of pathogen inhibition. Rhizosphere. 2021;17:100278.10.1016/j.rhisph.2020.100278Search in Google Scholar
9 Sharma N, Sharma KP, Gaur RK, Gupta VK. Role of chitinase in plant defense. Asian J Biochem. 2011;6:29–37.10.3923/ajb.2011.29.37Search in Google Scholar
10 Hartl L, Zach S, Seidl-Seiboth V. Fungal chitinases: diversity, mechanistic properties and biotechnological potential. Appl Microbiol Biotechnol. 2012;93:533–43.10.1007/s00253-011-3723-3Search in Google Scholar PubMed PubMed Central
11 Glick BR. The enhancement of plant growth by free-living bacteria. Can J Microbiol. 1995;41:109–17.10.1139/m95-015Search in Google Scholar
12 Dukare A, Paul S, Arambam A. Isolation and efficacy of native chitinolytic rhizobacteria for biocontrol activities against Fusarium wilt and plant growth promotion in pigeon pea (Cajanus cajan L.). Egypt J Biol Pest Control. 2020;30:1–12.10.1186/s41938-020-00256-7Search in Google Scholar
13 Castaldi S, Petrillo C, Donadio G, Piaz FD, Cimmino A, Masi M, et al. Plant growth promotion function of bacillus sp. strains isolated from salt-pan rhizosphere and their biocontrol potential against Macrophomina phaseolina. Int J Mol Sci. 2021;22:3324.10.3390/ijms22073324Search in Google Scholar PubMed PubMed Central
14 Li H, Wang X, Han M, Zhao Z, Wang M, Tang Q, et al. Endophytic Bacillus subtilis ZZ120 and its potential application in control of replant diseases. Afr J Biotechnol. 2012;11:231–42.10.5897/AJB11.2839Search in Google Scholar
15 Ehling-Schulz M, Lereclus D, Koehler TM. The Bacillus cereus group: Bacillus species with pathogenic potential. Microbiol Spectr. 2019;7:7–3.10.1128/microbiolspec.GPP3-0032-2018Search in Google Scholar PubMed PubMed Central
16 Xu J-X, Li Z-Y, Lv X, Yan H, Zhou G-Y, Cao L-X, et al. Isolation and characterization of Bacillus subtilis strain 1-L-29, an endophytic bacteria from Camellia oleifera with antimicrobial activity and efficient plant-root colonization. PLoS One. 2020;15:e0232096.10.1371/journal.pone.0232096Search in Google Scholar PubMed PubMed Central
17 Islam MA, Nain Z, Alam MK, Banu NA, Islam MR. In vitro study of biocontrol potential of rhizospheric Pseudomonas aeruginosa against Fusarium oxysporum f. sp. cucumerinum. Egyptian journal of Biological. Pest Control. 2018;28:1–11.10.1186/s41938-018-0097-1Search in Google Scholar
18 Fernández Gamarra MA, Maidana Ojeda M, Enciso, Maldonado GA. Molecular identification and growth rate of native strains of Trichoderma spp. isolated from the Northern Region of Paraguay. Invest Agraria. 2017;19:127–32.10.18004/investig.agrar.2017.diciembre.127-132Search in Google Scholar
19 Matarese F, Sarrocco S, Gruber S, Seidl-Seiboth V, Vannacci G. Biocontrol of Fusarium head blight: interactions between Trichoderma and mycotoxigenic Fusarium. Microbiology. 2012;158:98–106.10.1099/mic.0.052639-0Search in Google Scholar PubMed
20 Larralde-Corona CP, Santiago-Mena MR, Sifuentes-Rincon AM, Rodríguez-Luna IC, Rodriguez-Perez MA, Shirai K, et al. Biocontrol potential and polyphasic characterization of novel native Trichoderma strains against Macrophomina phaseolina isolated from sorghum and common bean. Appl Microbiol Biotechnol. 2008;80:167–77.10.1007/s00253-008-1532-0Search in Google Scholar PubMed
21 Yadav AK, Yandigeri MS, Vardhan S, Sivakumar G, Rangeshwaran R, Tripathi CPM. Streptomyces sp. S160: a potential antagonist against chickpea charcoal root rot caused by Macrophomina phaseolina (Tassi) Goid. Ann Microbiol. 2014;64:1113–22.10.1007/s13213-013-0750-6Search in Google Scholar
22 Anitha A, Rabeeth M. Control of Fusarium wilt of tomato by bioformulation of Streptomyces griseus in green house condition. Afr J Basic Appl Sci. 2009;1:9–14.Search in Google Scholar
23 Kim JD, Han JW, Lee SC, Lee D, Hwang IC, Kim BS. Disease control effect of strevertenes produced by Streptomyces psammoticus against tomato Fusarium wilt. J Agric Food Chem. 2011;59:1893–9.10.1021/jf1038585Search in Google Scholar PubMed
24 Getha K, Vikineswary S. Antagonistic effects of Streptomyces violaceusniger strain G10 on Fusarium oxysporum f. sp. cubense race 4: indirect evidence for the role of antibiosis in the antagonistic process. J Ind Microbiol Biotechnol. 2002;28:303–10.10.1038/sj.jim.7000247Search in Google Scholar
25 Shrivastava P, Kumar R, Yandigeri MS. In vitro biocontrol activity of halotolerant Streptomyces aureofaciens K20: a potent antagonist against Macrophomina phaseolina (Tassi) Goid. Saudi J Biol Sci. 2017;24:192–9.10.1016/j.sjbs.2015.12.004Search in Google Scholar PubMed PubMed Central
26 Gajbhiye A, Rai AR, Meshram SU, Dongre AB. Isolation, evaluation and characterization of Bacillus subtilis from cotton rhizospheric soil with biocontrol activity against Fusarium oxysporum. World J Microbiol Biotechnol. 2010;26:1187–94.10.1007/s11274-009-0287-9Search in Google Scholar PubMed
27 Zhao L, Jha BK, Wu A, Elliott R, Ziebuhr J, Gorbalenya AE, et al. Antagonism of the interferon-induced OAS-RNase L pathway by murine coronavirus ns2 protein is required for virus replication and liver pathology. Cell Host Microbe. 2012;11:607–16.10.1016/j.chom.2012.04.011Search in Google Scholar PubMed PubMed Central
28 Wang B, Yuan J, Zhang J, Shen Z, Zhang M, Li R, et al. Effects of novel bioorganic fertilizer produced by Bacillus amyloliquefaciens W19 on antagonism of Fusarium wilt of banana. Biol Fertil Soils. 2013;49:435–46.10.1007/s00374-012-0739-5Search in Google Scholar
29 Faheem M, Raza W, Zhong W, Nan Z, Shen Q, Xu Y. Evaluation of the biocontrol potential of Streptomyces goshikiensis YCXU against Fusarium oxysporum f. sp. niveum. Biol Control. 2015;81:101–10.10.1016/j.biocontrol.2014.11.012Search in Google Scholar
30 Adrio JL, Arnold LD. Genetic improvement of processes yielding microbial products. FEMS Microbiol Rev. 2006;30(2):187–214.10.1111/j.1574-6976.2005.00009.xSearch in Google Scholar PubMed
31 Liu J, Liu M, Wang J, Yao JM, Pan RR, Yu ZL. Enhancement of the Gibberella zeae growth inhibitory lipopeptides from a Bacillus subtilis mutant by ion beam implantation. Appl Microbiol Biotechnol. 2005;69:223–8.10.1007/s00253-005-1981-7Search in Google Scholar PubMed
32 Afsharmanesh H, Ahmadzadeh M, Majdabadi A, Motamedi F, Behboudi K, Javan-Nikkhah M. Enhancement of biosurfactants and biofilm production after gamma irradiation-induced mutagenesis of Bacillus subtilis UTB1, a biocontrol agent of Aspergillus flavus. Arch Phytopathol Plant Prot. 2013;46:1874–84.10.1080/03235408.2013.780374Search in Google Scholar
33 Afsharmanesh H, Ahmadzadeh M, Javan-Nikkhah M, Behboudi K. Improvement in biocontrol activity of Bacillus subtilis UTB1 against Aspergillus flavus using gamma-irradiation. Crop Prot. 2014;60:83–92.10.1016/j.cropro.2014.02.013Search in Google Scholar
34 Abbasi S, Safaie N, Shams-Bakhsh M, Shahbazi S. Biocontrol activities of gamma induced mutants of Trichoderma harzianum against some soilborne fungal pathogens and their DNA fingerprinting. Iran J Biotechnol. 2016;14:260.10.15171/ijb.1224Search in Google Scholar PubMed PubMed Central
35 Soufi E, Safaie N, Shahbazi S, Mojerlou S. Gamma irradiation induces genetic variation and boosting antagonism in Trichoderma aureoviride. Arch Phytopathol Plant Prot. 2021;54:1649–74. 10.1080/03235408.2021.1936377.Search in Google Scholar
36 Mukherjee PK, Mendoza-Mendoza A, Zeilinger S, Horwitz BA. Mycoparasitism as a mechanism of Trichoderma-mediated suppression of plant diseases. Fungal Biol Rev. 2022;39:15–33.10.1016/j.fbr.2021.11.004Search in Google Scholar
37 Khaliq S, Akhtar K, Ghauri MA, Iqbal R, Khalid AM, Muddassar M. Change in colony morphology and kinetics of tylosin production after UV and gamma irradiation mutagenesis of Streptomyces fradiae NRRL-2702. Microbiol Res. 2009;164:469–77.10.1016/j.micres.2007.02.005Search in Google Scholar PubMed
38 Ibrahim AA, Aboshanab KM, Yassien MA, Hassouna NA. Improvement of paromomycin production by Streptomyces rimosus subsp paromomycinus NRRL 2455 using gamma irradiation mutagenesis. Arch Pharm Sci Ain Shams Univ. 2017;1:26–30.10.21608/aps.2017.11017Search in Google Scholar
39 Lazim H, Slama N, Mankai H, Barkallah I, Limam F. Enhancement of oxytetracycline production after gamma irradiation-induced mutagenesis of Streptomyces rimosus CN08 strain. World J Microbiol Biotechnol. 2010;26:1317–22.10.1007/s11274-009-0303-0Search in Google Scholar PubMed
40 Gomaa EZ, El-Mahdy OM. Improvement of chitinase production by Bacillus thuringiensis NM101-19 for antifungal biocontrol through physical mutation. Microbiology. 2018;87:472–85.10.1134/S0026261718040094Search in Google Scholar
41 Khan N, Martínez-Hidalgo P, Ice TA, Maymon M, Humm EA, Nejat N, Sanders ER, Kaplan D, Hirsch AM. Antifungal Activity of Bacillus Species Against Fusarium and Analysis of the Potential Mechanisms Used in Biocontrol. Front. Microbiol. 2018;9:2363. 10.3389/fmicb.2018.02363Q20.Search in Google Scholar
42 Gond SK, Bergen MS, Torres MS, White Jr JF. Endophytic Bacillus spp. produce antifungal lipopeptides and induce host defence gene expression in maize. Microbiol Res. 2015;172:79–87.10.1016/j.micres.2014.11.004Search in Google Scholar PubMed
43 Gordon SA, Weber RP. Colorimetric estimation of indoleacetic acid. Plant Physiol. 1951;26:192.10.1104/pp.26.1.192Search in Google Scholar PubMed PubMed Central
44 Bindel Connelly M, Young GM, Sloma A. Extracellular proteolytic activity plays a central role in swarming motility in Bacillus subtilis. J Bacteriol. 2004;186:4159–67.10.1128/JB.186.13.4159-4167.2004Search in Google Scholar PubMed PubMed Central
45 Wiwat C, Thaithanun S, Pantuwatana S, Bhumiratana A. Toxicity of chitinase-producing Bacillus thuringiensis ssp. kurstaki HD-1 (G) toward Plutella xylostella. J Invertebrate Pathol. 2000;76:270–7.10.1006/jipa.2000.4976Search in Google Scholar
46 Blumer-Schuette SE, Kataeva I, Westpheling J, Adams MWW, Kelly RM. Extremely thermophilic microorganisms for biomass conversion: status and prospects. Curr OpBiotechnol. 2008;19:210–7.10.1016/j.copbio.2008.04.007Search in Google Scholar
47 Passari AK, Leo VV, Chandra P, Kumar B, Nayak C, Hashem A, et al. Bioprospection of actinobacteria derived from freshwater sediments for their potential to produce antimicrobial compounds. Microb Cell Factories. 2018;17:1–14.10.1186/s12934-018-0912-0Search in Google Scholar
48 Pandey VN, Dubey NK. Antifungal potential of leaves and essential oils from higher plants against soil phytopathogens. Soil Biol Biochem. 1994;26:1417–21.10.1016/0038-0717(94)90226-7Search in Google Scholar
49 Fu J, Huang B. Involvement of antioxidants and lipid peroxidation in the adaptation of two cool-season grasses to localized drought stress. Environ Exp Bot. 2001;45:105–14.10.1016/S0098-8472(00)00084-8Search in Google Scholar
50 Park JM, Vinuselvi P, Lee SK. The mechanism of sugar-mediated catabolite repression of the propionate catabolic genes in Escherichia coli. Gene. 2012;504:116–21.10.1016/j.gene.2012.04.074Search in Google Scholar
51 Lee H-J, Park K-H, Shim J-H, Park R-D, Kim Y-W, Cho J-Y, et al. Quantitative changes of plant defense enzymes in biocontrol of pepper (Capsicium annuum L.) late blight by antagonistic Bacillus subtilis. J Microbiol Biotechnol. 2005;15:1073–9.Search in Google Scholar
52 Parekh S, Vinci VA, Strobel RJ. Improvement of microbial strains and fermentation processes. Appl Microbiol Biotechnol. 2000;54(3):287–301.10.1007/s002530000403Search in Google Scholar
53 Spadaro D, Gullino ML. Improving the efficacy of biocontrol agents against soilborne pathogens. Crop Prot. 2005;24:601–13.10.1016/j.cropro.2004.11.003Search in Google Scholar
54 Baltz RH. Genetic methods and strategies for secondary metabolite yield improvement in actinomycetes. Antonie Van Leeuwenhoek. 2001;79:251–9.10.1023/A:1012020918624Search in Google Scholar
55 Mukherjee PK, Mehetre ST, Sherkhane PD, Muthukathan G, Ghosh A, Kotasthane AS, et al. A novel seed-dressing formulation based on an improved mutant strain of Trichoderma virens, and its field evaluation. Front Microbiol. 2019;10:1910.10.3389/fmicb.2019.01910Search in Google Scholar
56 Gong G, Zheng Z, Chen H, Yuan C, Wang P, Yao L, et al. Enhanced production of surfactin by Bacillus subtilis E8 mutant obtained by ion beam implantation. Food Technol Biotechnol. 2009;47:27–31.Search in Google Scholar
57 Ellaiah P, Prabhakar T, Ramakrishna B, Taleb AT, Adinarayana K. Strain improvement of Aspergillus niger for the production of lipase. Indian J Microbiol. 2002;42(2):151–4.Search in Google Scholar
58 Iftikhar TM, Niaz SQ, Abbas Z, Muhammad A, Ashraf I, Lee KJ, et al. Mutation induced enhanced biosynthesis of lipases by Rhizopus oligosporus var. microsporus. Pak J Bot. 2010;42(2):1235–49.Search in Google Scholar
59 Wijker CA, Lafleur MVM. “Influence of the UV-activated SOS response on the γ-radiation-induced mutation spectrum in the lacI gene.”. Mutat Res/DNA Repair. 1998;408(3):195–201.10.1016/S0921-8777(98)00034-2Search in Google Scholar
60 Versalovic J, Schneider M, De Bruijn FJ, Lupski JR. Genomic fingerprinting of bacteria using repetitive sequence-based polymerase chain reaction. Methods Mol Cell Biol. 1994;5:25–40.Search in Google Scholar
61 Haggag WM, Mohamed HAA. Enhanecment of antifungal metabolite production from gamma-ray induced mutants of some Trichoderma species for control onion white disease. Plant Pathol Bull. 2002;11:45–56.Search in Google Scholar
62 Farag MA, Ryu C-M, Sumner LW, Paré PW. GC–MS SPME profiling of rhizobacterial volatiles reveals prospective inducers of growth promotion and induced systemic resistance in plants. Phytochemistry. 2006;67:2262–8.10.1016/j.phytochem.2006.07.021Search in Google Scholar PubMed
63 Peypoux F, Guinand M, Michel G, Delcambe L, Das BC, Lederer E. Structure of iturine A, a peptidolipid antibiotic from Bacillus subtilis. Biochemistry. 1978;17:3992–6.10.1021/bi00612a018Search in Google Scholar PubMed
64 Cai X, Li H, Xue Y, Liu C. Study of endophytic Bacillus amyloliquefaciens CC09 and its antifungal cyclic lipopeptides. J Appl Biol Biotechnol. 2013;1:1–5.Search in Google Scholar
65 Kakinuma A, Hori M, Isono M, Tamura G, Arima K. Determination of amino acid sequence in surfactin, a crystalline peptidelipid surfactant produced by Bacillus subtilis. Agric Biol Chem. 1969;33:971–2.10.1080/00021369.1969.10859408Search in Google Scholar
66 Vanittanakom N, Loeffler W, Koch U, Jung G. Fengycin-a novel antifungal lipopeptide antibiotic produced by Bacillus subtilis F-29-3. J Antibiotics. 1986;39:888–901.10.7164/antibiotics.39.888Search in Google Scholar PubMed
67 Mehmood S, Muneer MA, Tahir M, Javed MT, Mahmood T, Afridi MS, et al. Deciphering distinct biological control and growth promoting potential of multi-stress tolerant Bacillus subtilis PM32 for potato stem canker. Physiol Mol Biol Plants. 2021;27:2101–14.10.1007/s12298-021-01067-2Search in Google Scholar PubMed PubMed Central
68 Lin Y, Du D, Si C, Zhao Q, Li Z, Li P. Potential biocontrol Bacillus sp. strains isolated by an improved method from vinegar waste compost exhibit antibiosis against fungal pathogens and promote growth of cucumbers. Biol Control. 2014;71:7–15.10.1016/j.biocontrol.2013.12.010Search in Google Scholar
69 Calvo P, Ormeño-Orrillo E, Martínez-Romero E, Zúñiga D. Characterization of Bacillus isolates of potato rhizosphere from andean soils of Peru and their potential PGPR characteristics. Braz J Microbiol. 2010;41:899–906.10.1590/S1517-83822010000400008Search in Google Scholar PubMed PubMed Central
70 Akgül DS, Mirik M. Biocontrol of Phytophthora capsici on pepper plants by Bacillus megaterium strains. J Plant Pathol. 2008;90:29–34.Search in Google Scholar
71 Aallam Y, Maliki BE, Dhiba D, Lemriss S, Souiri A, Haddioui A, et al. Multiple potential plant growth promotion activities of endemic Streptomyces spp. from moroccan sugar beet fields with their inhibitory activities against Fusarium spp. Microorganisms. 2021;9:1429.10.3390/microorganisms9071429Search in Google Scholar PubMed PubMed Central
72 Yandigeri MS, Meena KK, Singh D, Malviya N, Singh DP, Solanki MK, et al. Drought-tolerant endophytic actinobacteria promote growth of wheat (Triticum aestivum) under water stress conditions. Plant Growth Regul. 2012;68:411–20.10.1007/s10725-012-9730-2Search in Google Scholar
73 Singh SB, Gowtham HG, Murali M, Hariprasad P, Lakshmeesha TR, Murthy KN, et al. Plant growth promoting ability of ACC deaminase producing rhizobacteria native to Sunflower (Helianthus annuus L.). Biocatalysis Agric Biotechnol. 2019;18:101089.10.1016/j.bcab.2019.101089Search in Google Scholar
74 Misra S, Chauhan PS. ACC deaminase-producing rhizosphere competent Bacillus spp. mitigate salt stress and promote Zea mays growth by modulating ethylene metabolism. 3 Biotech. 2020;10:1–14.10.1007/s13205-020-2104-ySearch in Google Scholar PubMed PubMed Central
75 Nascimento FX, Rossi MJ, Glick BR. Role of ACC deaminase in stress control of leguminous plants. Plant growth promoting actinobacteria. Singapore: Springer; 2016. p. 179–92.10.1007/978-981-10-0707-1_11Search in Google Scholar
76 Dhar Purkayastha G, Mangar P, Saha A, Saha D. Evaluation of the biocontrol efficacy of a Serratia marcescens strain indigenous to tea rhizosphere for the management of root rot disease in tea. PLoS One. 2018;13:e0191761.10.1371/journal.pone.0191761Search in Google Scholar PubMed PubMed Central
77 Brzezinska MS, Kalwasińska A, Świątczak J, Żero K, Jankiewicz U. Exploring the properties of chitinolytic Bacillus isolates for the pathogens biological control. Microb Pathogenesis. 2020;148:104462.10.1016/j.micpath.2020.104462Search in Google Scholar PubMed
78 Abaidoo RC, Killani AS, Akintokun AK, Abiala MA. Antagonistic effect of indigenous Bacillus subtilis on root-/soil-borne fungal pathogens of cowpea. Researcher. 2011;3:11–18.Search in Google Scholar
79 Shekhar N, Bhattacharya D, Kumar D, Gupta RK. Biocontrol of wood-rotting fungi with Streptomyces violaceusniger XL-2. Can J Microbiol. 2006;52:805–8.10.1139/w06-035Search in Google Scholar PubMed
80 Palaniyandi SA, Yang SH, Zhang L, Suh J-W. Effects of actinobacteria on plant disease suppression and growth promotion. Appl Microbiol Biotechnol. 2013;97:9621–36.10.1007/s00253-013-5206-1Search in Google Scholar PubMed
81 Ryu C-M, Farag MA, Hu C-H, Reddy MS, Kloepper JW, Paré PW. Bacterial volatiles induce systemic resistance in Arabidopsis. Plant Physiol. 2004;134:1017–26.10.1104/pp.103.026583Search in Google Scholar PubMed PubMed Central
82 Gutiérrez-Luna FM, López-Bucio J, Altamirano-Hernández J, Valencia-Cantero E, de la Cruz HR, Macías-Rodríguez L. Plant growth-promoting rhizobacteria modulate root-system architecture in Arabidopsis thaliana through volatile organic compound emission. Symbiosis. 2010;51:75–83.10.1007/s13199-010-0066-2Search in Google Scholar
83 Podile AR, Laxmi VDV. Seed Bacterization with Bacillus subtilis AF 1 Increases Phenylalanine Ammonia‐lyase and Reduces the Incidence of Fusarial Wilt in Pigeonpea. J Phytopathol. 1998;146:255–9.10.1111/j.1439-0434.1998.tb04687.xSearch in Google Scholar
84 Kloepper JW, Ryu C-M, Zhang S. Induced systemic resistance and promotion of plant growth by Bacillus spp. Phytopathol. 2004;94:1259–66.10.1094/PHYTO.2004.94.11.1259Search in Google Scholar PubMed
85 Rais A, Jabeen Z, Shair F, Hafeez FY, Hassan MN. Bacillus spp., a bio-control agent enhances the activity of antioxidant defense enzymes in rice against Pyricularia oryzae. PLoS One. 2017;12:e0187412.10.1371/journal.pone.0187412Search in Google Scholar PubMed PubMed Central
86 Senthilraja G, Anand T, Kennedy JS, Raguchander T, Samiyappan R. Plant growth promoting rhizobacteria (PGPR) and entomopathogenic fungus bioformulation enhance the expression of defense enzymes and pathogenesis-related proteins in groundnut plants against leafminer insect and collar rot pathogen. Physiol Mol Plant Pathol. 2013;82:10–9.10.1016/j.pmpp.2012.12.002Search in Google Scholar
87 Bano A, Muqarab R. Plant defence induced by PGPR against Spodoptera litura in tomato (Solanum lycopersicum L.). Plant Biol. 2017;19:406–12.10.1111/plb.12535Search in Google Scholar PubMed
© 2022 Ariyan Manikandan et al., published by De Gruyter
This work is licensed under the Creative Commons Attribution 4.0 International License.
Articles in the same Issue
- Research Articles
- Diagnostic accuracy of genetic markers for identification of the Lr46/Yr29 “slow rusting” locus in wheat (Triticum aestivum L.)
- NADPH-derived ROS generation drives fibrosis and endothelial-to-mesenchymal transition in systemic sclerosis: Potential cross talk with circulating miRNAs
- Effect of omega-3 fatty acids on the telomere length: A mini meta-analysis of clinical trials
- Analysis of differentially expressed genes and signaling pathways involved in atherosclerosis and chronic obstructive pulmonary disease
- The epigenetic dimension of protein structure
- Gamma-induced mutants of Bacillus and Streptomyces display enhanced antagonistic activities and suppression of the root rot and wilt diseases in pulses
- Corticosterone potentiates ochratoxin A-induced microglial activation
- Supercomplex supercomplexes: Raison d’etre and functional significance of supramolecular organization in oxidative phosphorylation
- Insights into functional connectivity in mammalian signal transduction pathways by pairwise comparison of protein interaction partners of critical signaling hubs
- The effects of supplementation of Nannochloropsis oculata microalgae on biochemical, inflammatory and antioxidant responses in diabetic rats
- Molecular epidemiology of human papillomavirus in pregnant women in Burkina Faso
- Review Articles
- Interaction of cervical microbiome with epigenome of epithelial cells: Significance of inflammation to primary healthcare
- Seaweeds’ pigments and phenolic compounds with antimicrobial potential
- The capture of host cell’s resources: The role of heat shock proteins and polyamines in SARS-COV-2 (COVID-19) pathway to viral infection
- Erratum
- Erratum to “Plant growth-promoting properties of bacterial endophytes isolated from roots of Thymus vulgaris L. and investigate their role as biofertilizers to enhance the essential oil contents”
- Special Issue on XXV Congress of the Italian Society for Pure and Applied Biophysics
- Low-temperature librations and dynamical transition in proteins at differing hydration levels
- The phosphoinositide PI(3,5)P2 inhibits the activity of plant NHX proton/potassium antiporters: Advantages of a novel electrophysiological approach
- Targeted photoimmunotherapy for cancer
- Calorimetry of extracellular vesicles fusion to single phospholipid membrane
- Calcium signaling in prostate cancer cells of increasing malignancy
- Oxygen diffusion pathways in mutated forms of a LOV photoreceptor from Methylobacterium radiotolerans: A molecular dynamics study
- A photosensitizing fusion protein with targeting capabilities
- Ion channels and neuronal excitability in polyglutamine neurodegenerative diseases
- Is styrene competitive for dopamine receptor binding?
- Diffusion of molecules through nanopores under confinement: Time-scale bridging and crowding effects via Markov state model
- Quantitative active super-resolution thermal imaging: The melanoma case study
- Innovative light sources for phototherapy
- Electrophysiological study of the effects of side products of RuBi-GABA uncaging on GABAA receptors in cerebellar granule cells
- Subcellular elements responsive to the biomechanical activity of triple-negative breast cancer-derived small extracellular vesicles
Articles in the same Issue
- Research Articles
- Diagnostic accuracy of genetic markers for identification of the Lr46/Yr29 “slow rusting” locus in wheat (Triticum aestivum L.)
- NADPH-derived ROS generation drives fibrosis and endothelial-to-mesenchymal transition in systemic sclerosis: Potential cross talk with circulating miRNAs
- Effect of omega-3 fatty acids on the telomere length: A mini meta-analysis of clinical trials
- Analysis of differentially expressed genes and signaling pathways involved in atherosclerosis and chronic obstructive pulmonary disease
- The epigenetic dimension of protein structure
- Gamma-induced mutants of Bacillus and Streptomyces display enhanced antagonistic activities and suppression of the root rot and wilt diseases in pulses
- Corticosterone potentiates ochratoxin A-induced microglial activation
- Supercomplex supercomplexes: Raison d’etre and functional significance of supramolecular organization in oxidative phosphorylation
- Insights into functional connectivity in mammalian signal transduction pathways by pairwise comparison of protein interaction partners of critical signaling hubs
- The effects of supplementation of Nannochloropsis oculata microalgae on biochemical, inflammatory and antioxidant responses in diabetic rats
- Molecular epidemiology of human papillomavirus in pregnant women in Burkina Faso
- Review Articles
- Interaction of cervical microbiome with epigenome of epithelial cells: Significance of inflammation to primary healthcare
- Seaweeds’ pigments and phenolic compounds with antimicrobial potential
- The capture of host cell’s resources: The role of heat shock proteins and polyamines in SARS-COV-2 (COVID-19) pathway to viral infection
- Erratum
- Erratum to “Plant growth-promoting properties of bacterial endophytes isolated from roots of Thymus vulgaris L. and investigate their role as biofertilizers to enhance the essential oil contents”
- Special Issue on XXV Congress of the Italian Society for Pure and Applied Biophysics
- Low-temperature librations and dynamical transition in proteins at differing hydration levels
- The phosphoinositide PI(3,5)P2 inhibits the activity of plant NHX proton/potassium antiporters: Advantages of a novel electrophysiological approach
- Targeted photoimmunotherapy for cancer
- Calorimetry of extracellular vesicles fusion to single phospholipid membrane
- Calcium signaling in prostate cancer cells of increasing malignancy
- Oxygen diffusion pathways in mutated forms of a LOV photoreceptor from Methylobacterium radiotolerans: A molecular dynamics study
- A photosensitizing fusion protein with targeting capabilities
- Ion channels and neuronal excitability in polyglutamine neurodegenerative diseases
- Is styrene competitive for dopamine receptor binding?
- Diffusion of molecules through nanopores under confinement: Time-scale bridging and crowding effects via Markov state model
- Quantitative active super-resolution thermal imaging: The melanoma case study
- Innovative light sources for phototherapy
- Electrophysiological study of the effects of side products of RuBi-GABA uncaging on GABAA receptors in cerebellar granule cells
- Subcellular elements responsive to the biomechanical activity of triple-negative breast cancer-derived small extracellular vesicles